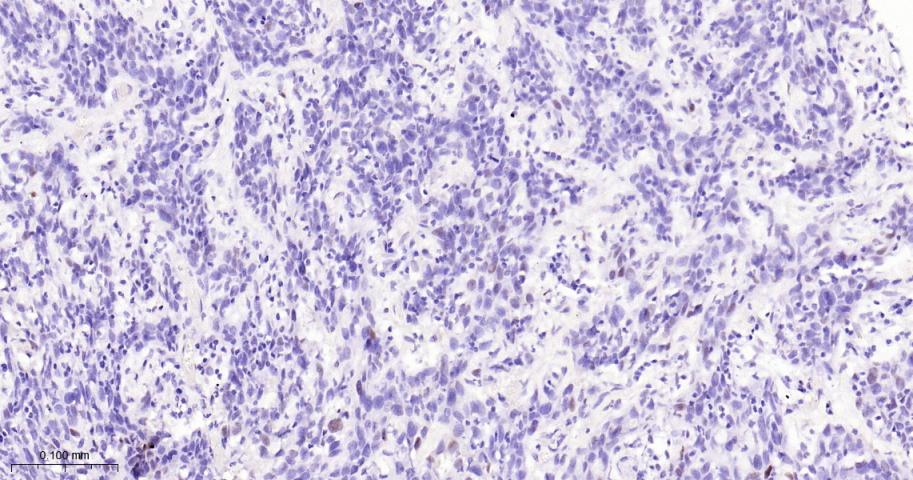
p21蛋白重组兔单抗
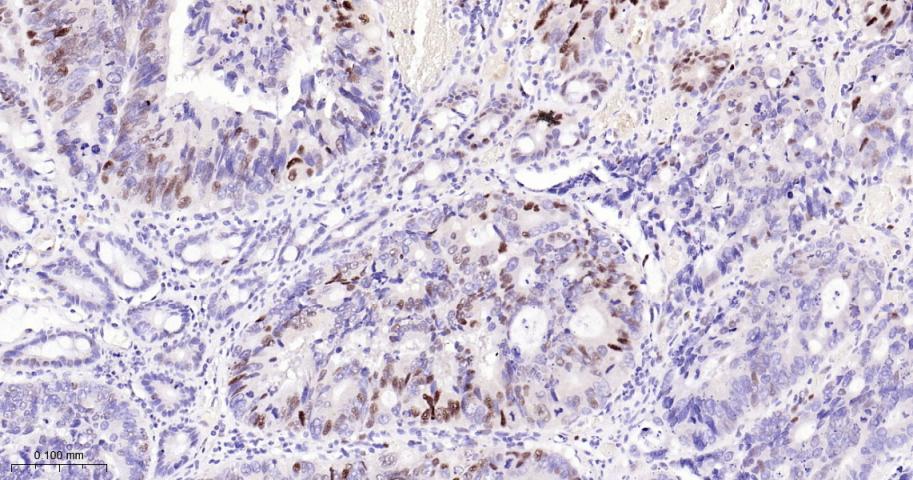
p21蛋白重组兔单抗

p21 Recombinant Rabbit mAb (一抗) - WB,IHC-P,IHC-F,IF,Flow-Cyt,ICC/IF | Bioss
Rrmab?兔单抗

货号:bsm-60698R
产品详情
相关标记
相关产品
相关文献
常见问题
概述
产品编号
bsm-60698R
产品类型
重组兔单抗
英文名称
p21 Recombinant Rabbit mAb
中文名称
p21蛋白重组兔单抗
英文别名
CAP20; CDKN1; CIP1; MDA-6; P21; SDI1; WAF1; p21CIP1; CDKI; mda6; p21WAF; UV96; CDN1A_HUMAN; CDKN1A; CDK-interacting protein 1; Melanoma differentiation-associated protein 6 (MDA-6); PIC1; CDN1A_MOUSE; Melanoma differentiation-associated protein; cyclin dependent kinase inhibitor 1A; cyclin-dependent kinase inhibitor 1A (p21, Cip1)
抗体来源
Rabbit
免疫原
A synthesized peptide derived from human CDKN1A: 50-90
亚型
IgG
性状
Liquid
纯化方法
affinity purified by Protein A
克隆类型
Recombinant
克隆号
R5H7
理论分子量
18 kDa
检测分子量
18 kDa
浓度
1mg/ml
储存液
0.01M TBS (pH7.4) with 1% BSA, 0.02% Proclin300 and 50% Glycerol.
研究领域
Cell Biology > Cell Cycle > Cell Cycle Inhibitors > Cip / Kip
Epigenetics and Nuclear Signaling > Cell cycle > Cell Cycle Inhibitors > Cip/Kip
Epigenetics and Nuclear Signaling > Chromatin Binding Proteins > DNA / RNA binding
Epigenetics and Nuclear Signaling > Nuclear Signaling Pathways > Nuclear Receptors > Co-activators/co-repressors
Epigenetics and Nuclear Signaling > Transcription > Domain Families > Zinc Finger
Signal Transduction > Signaling Pathway > Nuclear Signaling > Nuclear Hormone Receptors > Co-activators/co-repressors
SWISS
Gene ID
保存条件
Shipped at 4℃. Store at -20℃ for one year. Avoid repeated freeze/thaw cycles.
注意事项
This product as supplied is intended for research use only, not for use in human, therapeutic or diagnostic applications.
数据库链接
产品介绍
p21蛋白的过度表达与肿瘤的类型、恶性度、分期以及病人的预后密切相关。主要用于胃肠道癌肿、乳腺癌、肺癌等恶性肿瘤的研究。
背景资料
This gene encodes a potent cyclin-dependent kinase inhibitor. The encoded protein binds to and inhibits the activity of cyclin-CDK2 or -CDK4 complexes, and thus functions as a regulator of cell cycle progression at G1. The expression of this gene is tightly controlled by the tumor suppressor protein p53, through which this protein mediates the p53-dependent cell cycle G1 phase arrest in response to a variety of stress stimuli. This protein can interact with proliferating cell nuclear antigen (PCNA), a DNA polymerase accessory factor, and plays a regulatory role in S phase DNA replication and DNA damage repair. This protein was reported to be specifically cleaved by CASP3-like caspases, which thus leads to a dramatic activation of CDK2, and may be instrumental in the execution of apoptosis following caspase activation. Two alternatively spliced variants, which encode an identical protein, have been reported. Two families of cyclin dependent kinase inhibitors (CKIs) have been identified. The p21WAF1/Cip1 family inhibits all kinases involved in the G1/S transition. The p16INK4a family inhibits Cdk4 and Cdk6 specifically.

产品应用
| 应用 | 已检合格种属 | 预测种属 | 推荐稀释比例 |
|---|---|---|---|
| WB | Human | 1:500-2000 | |
| IHC-P | Human | 1:50-200 | |
| IHC-F | Human | 1:50-200 | |
| IF | Human | 1:50-200 | |
| Flow-Cyt | Human | 1:50-100 | |
| ICC/IF | Human | 1:50-200 |
交叉反应
交叉反应: Human
相关产品
暂无相关产品
靶标
基因名
CDKN1A
蛋白名
Cyclin-dependent kinase inhibitor 1
亚基
Interacts with HDAC1; the interaction is prevented by competitive binding of C10orf90/FATS to HDAC1 facilitating acetylation and protein stabilization of CDKN1A/p21. Interacts with MKRN1. Interacts with PSMA3. Interacts with PCNA. Component of the ternary complex, cyclin D-CDK4-CDKN1A. Interacts (via its N-terminal domain) with CDK4; the interaction promotes the assembly of the cyclin D-CDK4 complex, its nuclear translocation and promotes the cyclin D-dependent enzyme activity of CDK4. Binding to CDK2 leads to CDK2/cyclin E inactivation at the G1-S phase DNA damage checkpoint, thereby arresting cells at the G1-S transition during DNA repair. Interacts with PIM1.
亚细胞定位
Cytoplasmic and Nuclear.
组织特异性
Expressed in all adult tissues, with 5-fold lower levels observed in the brain.
翻译后修饰
Phosphorylation of Thr-145 by Akt or of Ser-146 by PKC impairs binding to PCNA. Phosphorylation at Ser-114 by GSK3-beta enhances ubiquitination by the DCX(DTL) complex. Phosphorylation of Thr-145 by PIM2 enhances CDKN1A stability and inhibits cell proliferation. Phosphorylation of Thr-145 by PIM1 results in the relocation of CDKN1A to the cytoplasm and enhanced CDKN1A protein stability.
Ubiquitinated by MKRN1; leading to polyubiquitination and 26S proteasome-dependent degradation. Ubiquitinated by the DCX(DTL) complex, also named CRL4(CDT2) complex, leading to its degradation during S phase or following UV irradiation. Ubiquitination by the DCX(DTL) complex is essential to control replication licensing and is PCNA-dependent: interacts with PCNA via its PIP-box, while the presence of the containing the 'K+4' motif in the PIP box, recruit the DCX(DTL) complex, leading to its degradation.
Acetylation leads to protein stability. Acetylated in vitro on Lys-141, Lys-154, Lys-161 and Lys-163. Deacetylation by HDAC1 is prevented by competitive binding of C10orf90/FATS to HDAC1.
Ubiquitinated by MKRN1; leading to polyubiquitination and 26S proteasome-dependent degradation. Ubiquitinated by the DCX(DTL) complex, also named CRL4(CDT2) complex, leading to its degradation during S phase or following UV irradiation. Ubiquitination by the DCX(DTL) complex is essential to control replication licensing and is PCNA-dependent: interacts with PCNA via its PIP-box, while the presence of the containing the 'K+4' motif in the PIP box, recruit the DCX(DTL) complex, leading to its degradation.
Acetylation leads to protein stability. Acetylated in vitro on Lys-141, Lys-154, Lys-161 and Lys-163. Deacetylation by HDAC1 is prevented by competitive binding of C10orf90/FATS to HDAC1.
相似性
Belongs to the CDI family.
功能
May be the important intermediate by which p53/TP53 mediates its role as an inhibitor of cellular proliferation in response to DNA damage. Binds to and inhibits cyclin-dependent kinase activity, preventing phosphorylation of critical cyclin-dependent kinase substrates and blocking cell cycle progression. Functions in the nuclear localization and assembly of cyclin D-CDK4 complex and promotes its kinase activity towards RB1. At higher stoichiometric ratios, inhibits the kinase activity of the cyclin D-CDK4 complex.
同靶标产品
相关文献
提示: 发表研究结果有使用 bsm-60698R 时请让我们知道,以便我们可以引用参考文章。作为回馈,资料提供者将获得我们送上的小礼品。
具体参考文献:bsm-60698R 被引用于4文献中